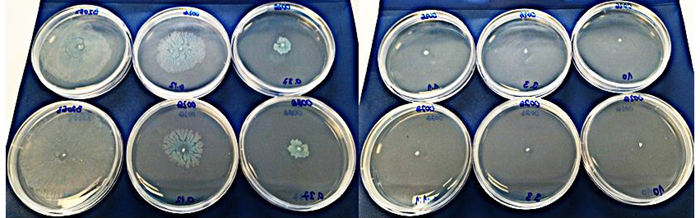

This article and associated images are based on a poster originally authored by Rory Triniman, Tim Lindsay, Nelson Lam, and Eddie French and presented at ELRIG Drug Discovery 2025 in affiliation with Veirulence.
This poster is being hosted on this website in its raw form, without modifications. It has not undergone peer review but has been reviewed to meet AZoNetwork's editorial quality standards. The information contained is for informational purposes only and should not be considered validated by independent peer assessment.

Background
Antibiotics are the only treatment option for bacterial infections, targeting just a few essential systems. However, bacterial virulence factors (VFs) have increasingly been validated as drug targets with strong clinical relevance.1-3 Neutralizing VFs have potential as a new modality to address the challenge of antibiotic resistance.
Swarming: A virulent lifestyle
Opportunistic pathogens dramatically change phenotypes for different “lifestyle” choices – motile and virulent or biofilm and chronic persistence. These lifestyle switches are regulated at a global and localized level by c-di-GMP.
Swarming motility is a validated acute virulence determinant, with a swarming phenotype observed in most infection isolates.
Table 1. Swarming phenotype prevalence in a cohort of P. aeruginosa clinical isolates.4 Source: Table adapted from Murray et al., 2010
| Culture Site (P. aeruginosa) |
Swarm-positive phenotype [n (%)] |
| Respiratory (136) |
75 (57) |
| Urine (65) |
41 (63) |
| Wound (22) |
16 (76) |
| Blood (14) |
11 (85) |
| Total (227) |
143 (63) |
Veirulence is developing a first-in-class small molecule that targets a core genome regulator of c-di-GMP to treat acute Gram-negative bloodstream infections.
The mechanism results in dose-dependent inhibition of swarming but also provides additional therapeutic benefits by preventing a virulent lifestyle in P. aeruginosa.
Swarming inhibition vs MDR P. aeruginosa clinical isolates
Figure 1. Dose-dependent swarming inhibition by VEI-0026 against multi-drug resistant (MDR) P. aeruginosa clinical isolate (trachea). IC50 ~200 nM. The result is representative of efficacy against MDR isolates of sputum, urinary tract, skin, and wound infections. All tested isolates are resistant to β-lactams (including carbapenems), aminoglycosides, and fluoroquinolones. Image Credit: Image courtesy of Rory Triniman et al., in partnership with ELRIG (UK) Ltd.
MIC values (μg/mL):
| Compounds |
PAO1 |
| VEI-0026 |
>80* |
| Ampicillin |
>64 |
| Ceftazidime |
2 |
| Ciprofloxacin |
<0.125 |
| Tobramycin |
0.5 |
* μM

Figure 2. (Table) MIC values for VEI-0026 and common antibiotics. An MIC was not obtained for VEI-0026 at any tested concentration. (Graph) VEI-0026 does not inhibit the growth of P. aeruginosa at concentrations 10x higher than swarming EC100; prevention of swarming is not a result of cytotoxicity but selective disruption to c-di-GMP signalling. Image Credit: Image courtesy of Rory Triniman et al., in partnership with ELRIG (UK) Ltd.

Figure 3. Transcriptomic analysis of P. aeruginosa on a swarming plate treated with VEI-008 (vs untreated). Significant differentially expressed genes that play a key role within clinically relevant systems - T3SS, elastases, swarming, and antibiotic resistance - are highlighted to demonstrate a broad suppressive effect on P. aeruginosa acute virulence behavior. Image Credit: Image courtesy of Rory Triniman et al., in partnership with ELRIG (UK) Ltd.
Discussion
A growing body of literature is showing VFs have excellent therapeutic potential. However, research has focused on specific VFs to target. Here, we introduce our first-in-class approach, which disrupts c-di-GMP signalling and causes a broad suppression of a highly virulent and resistant lifestyle, characterized by swarming. Veirulence is in lead optimization with its lead series.
Future work will focus on mechanisms of potentiation with antibiotics and the development of translational animal models in our area of interest.
References
- Ciofu O, Johansen HK, Høiby N. (2022). LasB elastase expression contributes to airway colonization and early-stage infection in cystic fibrosis patients with Pseudomonas aeruginosa.
- Valik, J.K., et al. (2024). Genomic virulence markers are associated with severe outcomes in patients with Pseudomonas aeruginosa bloodstream infection. Communications Medicine, 4(1). DOI: 10.1038/s43856-024-00696-4. https://www.nature.com/articles/s43856-024-00696-4.
- Llanos, A., et al. (2023). Higher levels of Pseudomonas aeruginosa LasB elastase expression are associated with early-stage infection in cystic fibrosis patients. Scientific Reports, [online] 13(1), p.14208. DOI: 10.1038/s41598-023-41333-9. https://www.nature.com/articles/s41598-023-41333-9.
- Murray, T.S., Ledizet, M., and Kazmierczak, B.I. (2010). Swarming motility, secretion of type 3 effectors, and biofilm formation phenotypes were exhibited within a large cohort of Pseudomonas aeruginosa clinical isolates. Journal of Medical Microbiology, 59(5), pp.511–520. DOI: 10.1099/jmm.0.017715-0. https://www.microbiologyresearch.org/content/journal/jmm/10.1099/jmm.0.017715-0.
About Veirulence Ltd.
Veirulence Ltd. is a UK-based biopharmaceutical startup pioneering a first-in-class, non-antibiotic therapeutic approach to combat bacterial infections and the growing global challenge of antimicrobial resistance (AMR).
About ELRIG (UK) Ltd.
The European Laboratory Research & Innovation Group (ELRIG) is a leading European not-for-profit organization that exists to provide outstanding scientific content to the life science community. The foundation of the organization is based on the use and application of automation, robotics, and instrumentation in life science laboratories, but over time, we have evolved to respond to the needs of biopharma by developing scientific programs that focus on cutting-edge research areas that have the potential to revolutionize drug discovery.
Comprised of a global community of over 12,000 life science professionals, participating in our events, whether it be at one of our scientific conferences or one of our networking meetings, will enable any of our community to exchange information, within disciplines and across academic and biopharmaceutical organizations, on an open access basis, as all our events are free of charge to attend!
Our values
Our values are to always ensure the highest quality of content, that content will be made readily accessible to all, and that we will always be an inclusive organization, serving a diverse scientific network. In addition, ELRIG will always be a volunteer led organization, run by and for the life sciences community, on a not-for-profit basis.
Our purpose
ELRIG is a company whose purpose is to bring the life science and drug discovery communities together to learn, share, connect, innovate, and collaborate on an open-access basis. We achieve this through the provision of world-class conferences, networking events, webinars, and digital content.
Sponsored Content Policy: News-Medical.net publishes articles and related content that may be derived from sources where we have existing commercial relationships, provided such content adds value to the core editorial ethos of News-Medical.net, which is to educate and inform site visitors interested in medical research, science, medical devices, and treatments.
Last Updated: Dec 12, 2025